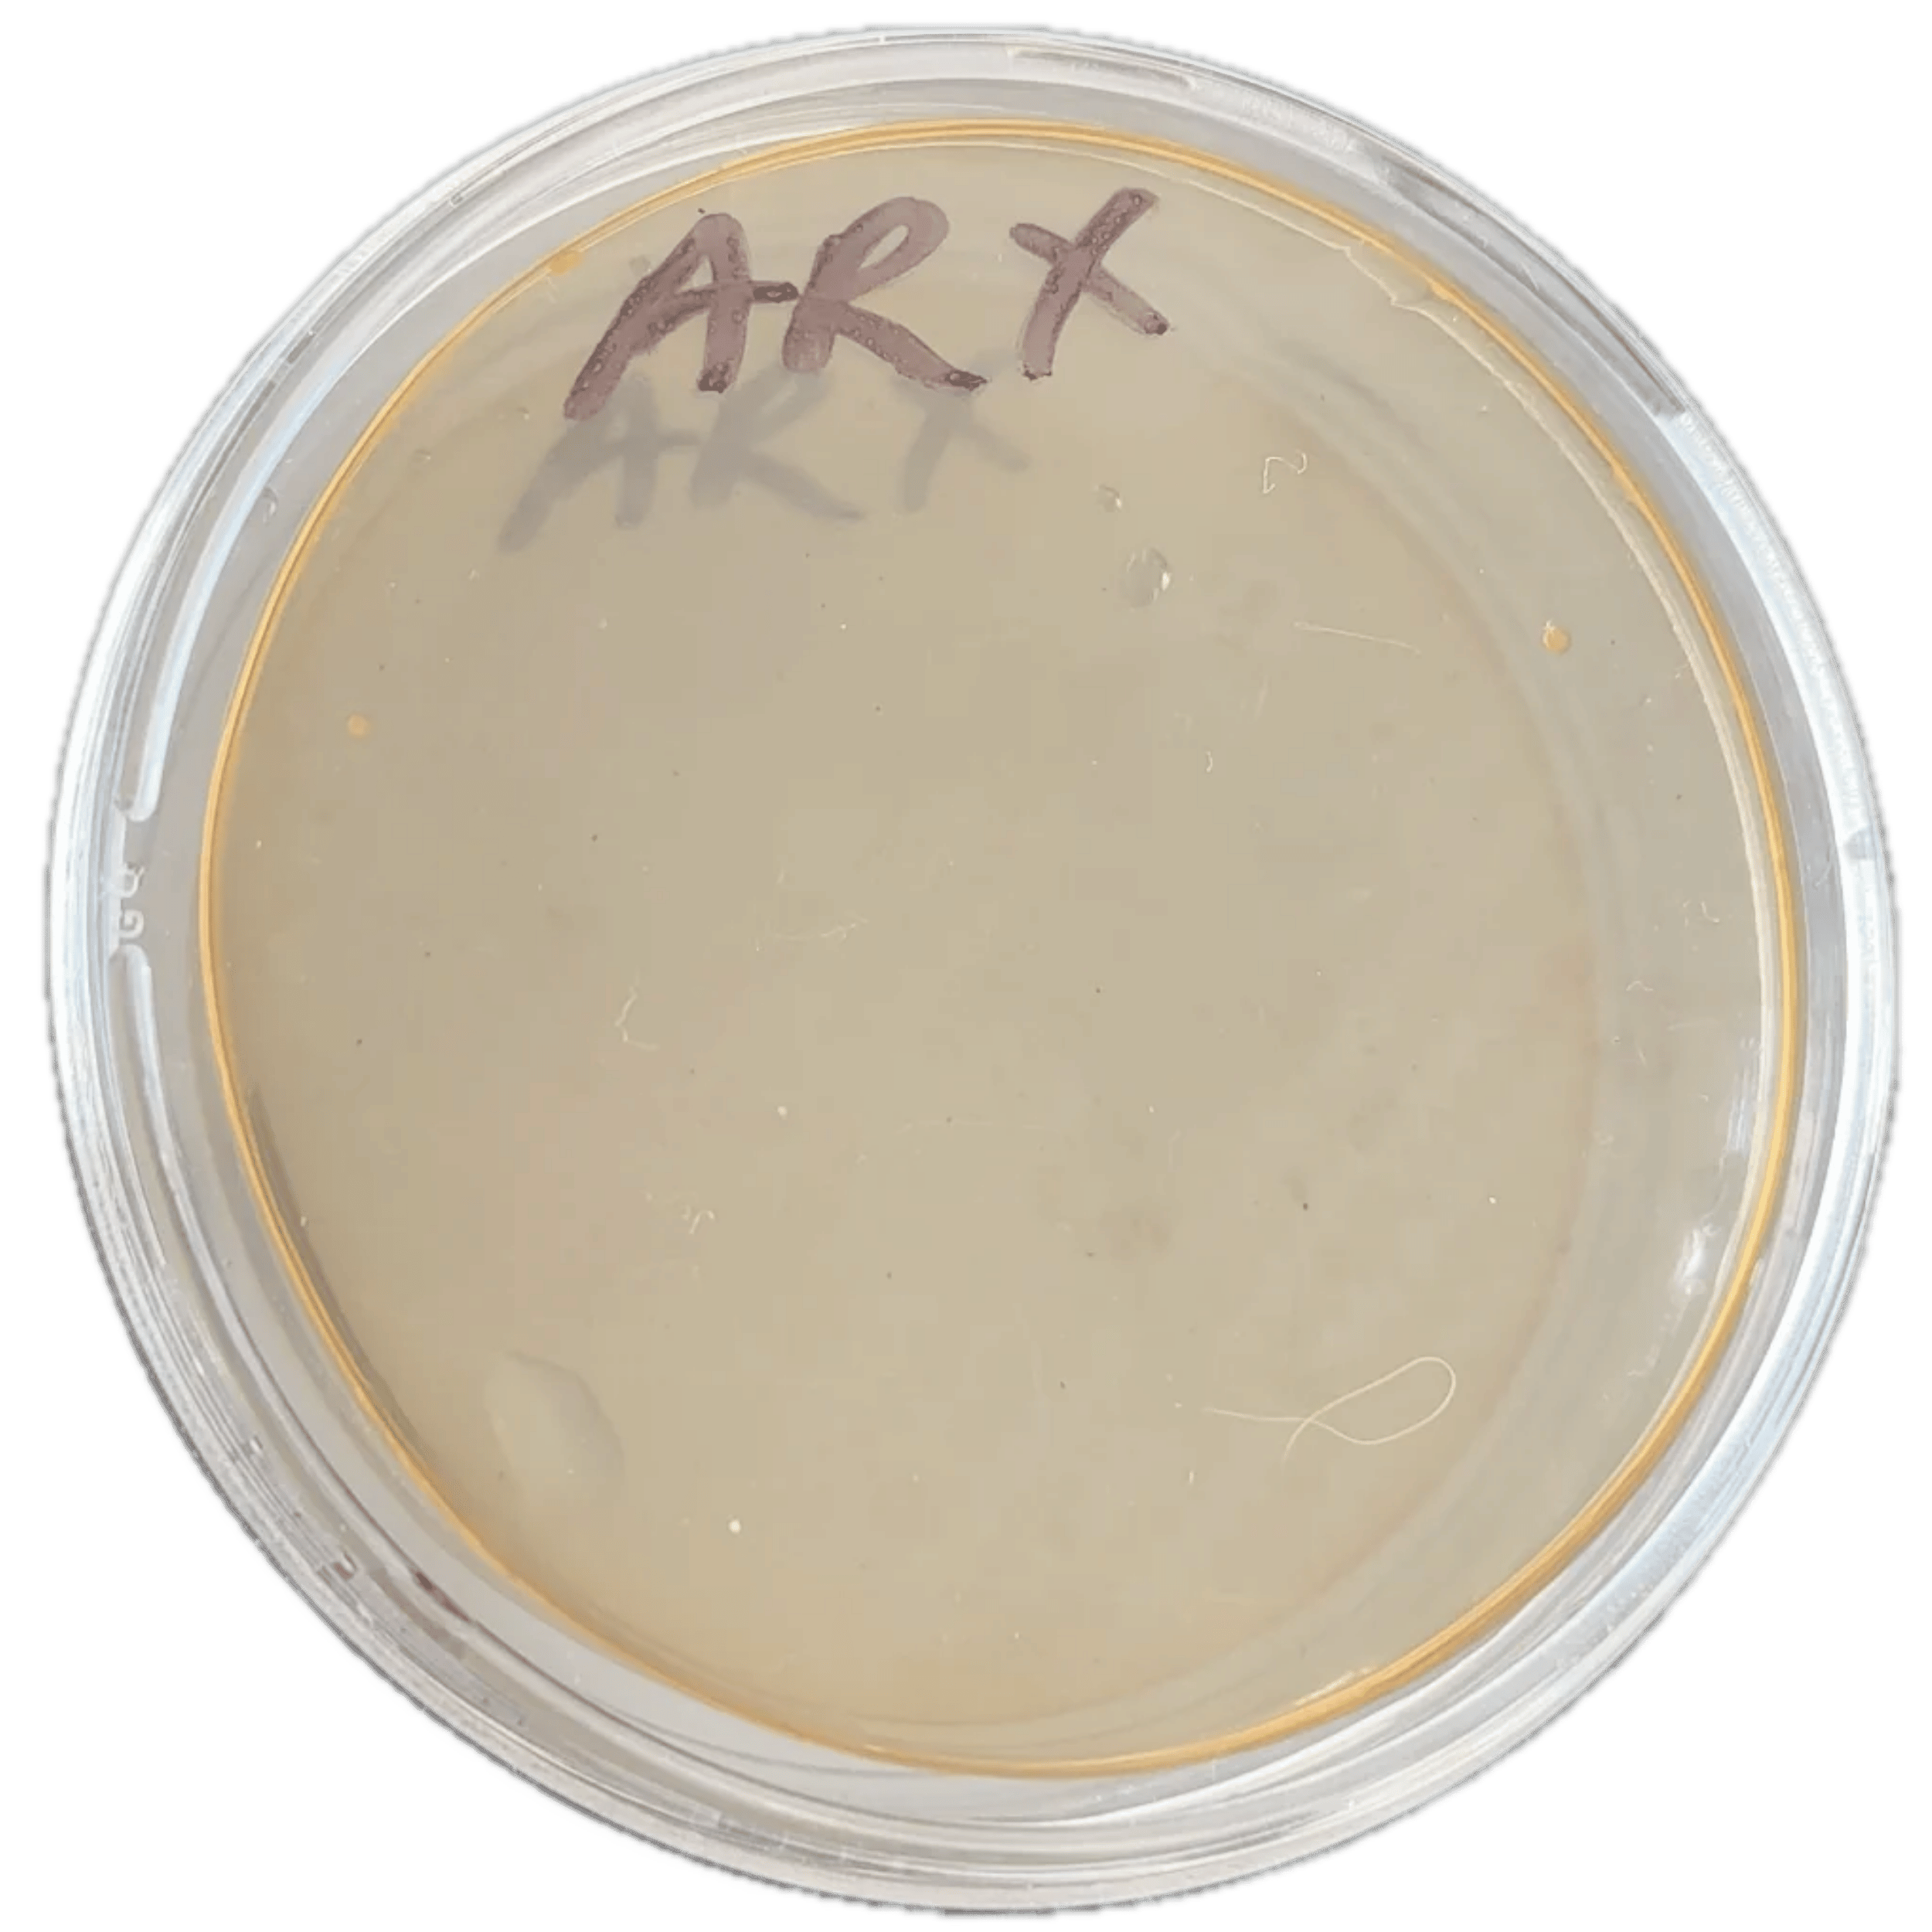

How long will one pack of laundry sheet last?

Antifungal + Antibacterial

Eliminates Odours

14 Day Money
Back Guarantee

Free Shipping With Subscriptions

Antifungal + Antibacterial

Eliminates Odours

14 Day Money
Back Guarantee

Free Shipping On Subscription Orders
Boost Your Confidence with Cleaner Clothes






Harnessing A Centuries Old Element To Keep You Clean






Boost Your Confidence with Cleaner Clothes

Harnessing A Centuries Old Element To Keep You Clean





